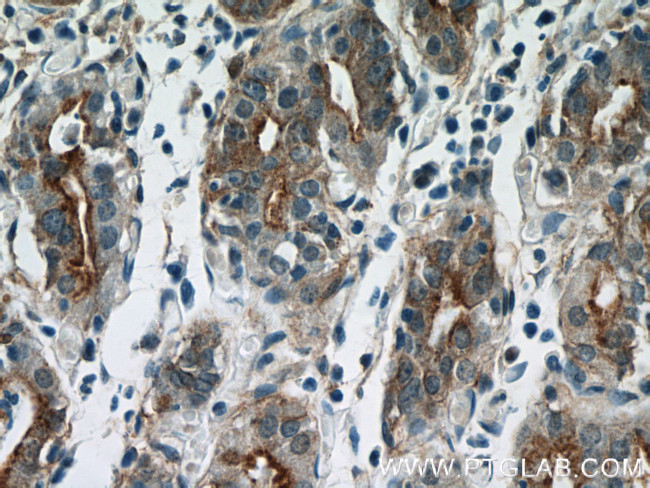
Annexin IV Antibody in Immunohistochemistry (Paraffin) (IHC (P))

Search
Proteintech
Annexin IV Polyclonal Antibody
{{$productOrderCtrl.translations['antibody.pdp.commerceCard.promotion.promotions']}}
{{$productOrderCtrl.translations['antibody.pdp.commerceCard.promotion.viewpromo']}}
{{$productOrderCtrl.translations['antibody.pdp.commerceCard.promotion.promocode']}}: {{promo.promoCode}} {{promo.promoTitle}} {{promo.promoDescription}}. {{$productOrderCtrl.translations['antibody.pdp.commerceCard.promotion.learnmore']}}
产品信息
10087-1-AP
种属反应
已发表种属
宿主/亚型
分类
类型
抗原
偶联物
形式
浓度
规格
纯化类型
保存液
内含物
保存条件
运输条件
产品详细信息
Immunogen sequence: GTDEDAIIS VLAYRNTAQR QEIRTAYKST IGRDLIDDLK SELSGNFEQV IVGMMTPTVL YDVQELRRAM KGAGTDEGCL IEILASRTPE EIRRISQTYQ QQYGRSLEDD IRSDTSFMFQ RVLVSLSAGG RDEGNYLDDA LVRQDAQDLY EAGEKKWGTD EVKFLTVLCS R (33-202 aa encoded by BC000182)
靶标信息
Annexin IV (ANX4) belongs to the annexin family of calcium-dependent phospholipid binding proteins. Although their functions are still not clearly defined, several members of the annexin family have been implicated in membrane-related events along exocytotic and endocytotic pathways. ANX4 has 45 to 59% identity with other members of its family and shares a similar size and exon-intron organization. Isolated from human placenta, ANX4 encodes a protein that has possible interactions with ATP, and has in vitro anticoagulant activity and also inhibits phospholipase A2 activity. ANX4 is almost exclusively expressed in epithelial cells.
仅用于科研。不用于诊断过程。未经明确授权不得转售。
生物信息学
蛋白别名: 35-beta calcimedin; 36 kDa zymogen granule membrane-associated protein; Annexin A4; Annexin IV; annexin IV (placental anticoagulant protein II); Annexin-4; ANXA 4; ANXA4; Carbohydrate-binding protein p33/p41; Chromobindin-4; Endonexin I; epididymis secretory protein Li 274; Lipocortin IV; P32.5; PAP-II; Placental anticoagulant protein II; PP4-X; proliferation-inducing gene 28; proliferation-inducing protein 28; Protein II; unnamed protein product; ZAP 36/annexin IV; ZAP36
基因别名: AI265406; AIV; ANX4; ANXA4; AW106930; HEL-S-274; P32.5; PAP-II; PIG28; PP4-X; Xanx-4; ZAP36
UniProt ID: (Human) P09525, (Mouse) P97429
Entrez Gene ID: (Human) 307, (Rat) 79124, (Mouse) 11746